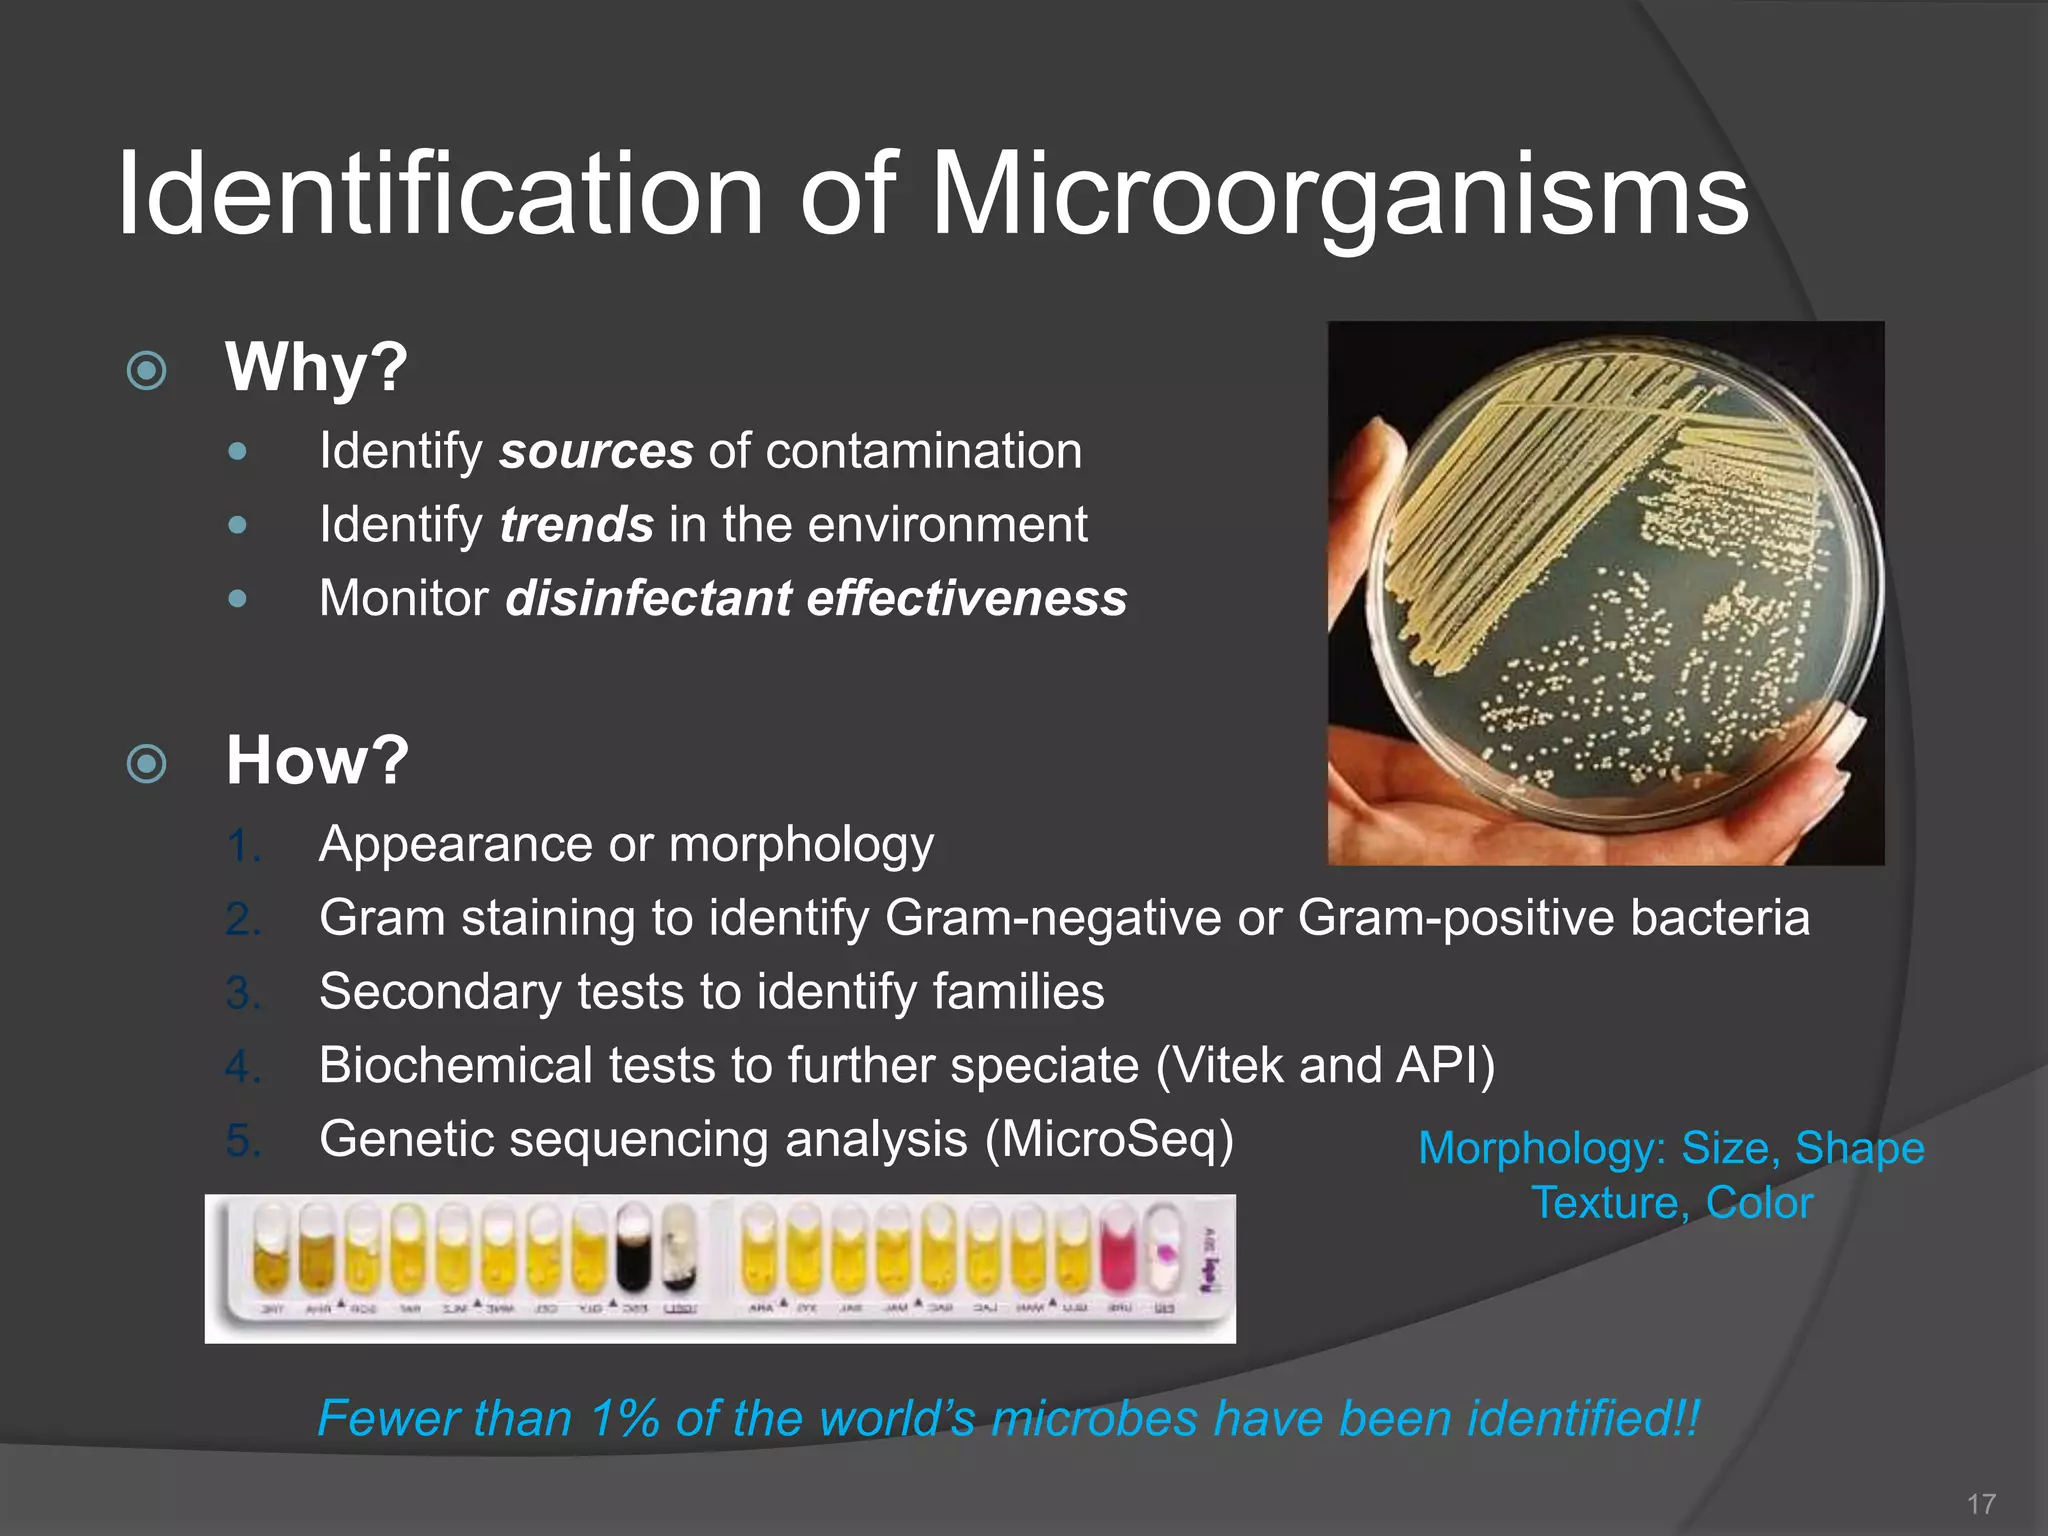
Identification of Microorganisms
 Why?
 Identify sources of contamination
 Identify trends in the environment
 Monitor disinfectant effectiveness
 How?
1. Appearance or morphology
2. Gram staining to identify Gram-negative or Gram-positive bacteria
3. Secondary tests to identify families
4. Biochemical tests to further speciate (Vitek and API)
5. Genetic sequencing analysis (MicroSeq)
17
Fewer than 1% of the world’s microbes have been identified!!
Morphology: Size, Shape
Texture, Color

The document provides an overview of aseptic practices and microbiology basics. It discusses:
- Definitions of aseptic, sterile, and related terms.
- A brief history of aseptic techniques and milestones like the development of the microscope, iodine, and HEPA filters.
- The importance of microbiology in contamination control and why microbes are studied. It describes common types of microbes like bacteria, fungi, and viruses.
- Sources of contamination and methods for contamination control including cleaning/disinfection, hygiene practices, facilities design with HEPA filters and air flow, and the four pillars of aseptic techniques.
- Personal responsibility in contamination prevention through practices like hand